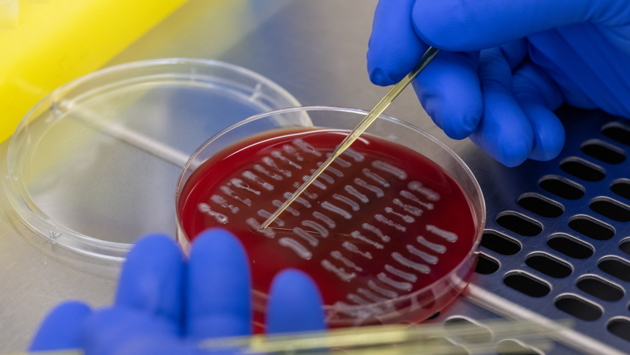

В России зарегистрирован первый отечественный препарат от оспы
Препарат для лечения взрослых от трех видов оспы НИОХ-14 разработали в центре “Вектор”. Теперь он официально зарегистрирован,
РИА Новости со ссылкой на данные государственного реестра лекарственных средств. Изобретенное лекарство предполагает лечение натуральной оспы, оспы обезьяньей и коровьей, а именно инфекций, ими вызванных. Как ингибиторы, вещества НИОХ-14 будут блокировать процесс формирования оболочки вируса, что нарушает его функционирование и обеспечивает процесс выздоровления. У препарата есть список противопоказаний. В частности, его нельзя применять детям, беременным, кормящим, а также тем, кто имеет непереносимость лактозы и лактозный дефицит. Ранее мы писали о том, что
ученые нашли лекарство от пищевой аллергии.
Загрузка…
Рамблер: главные новости